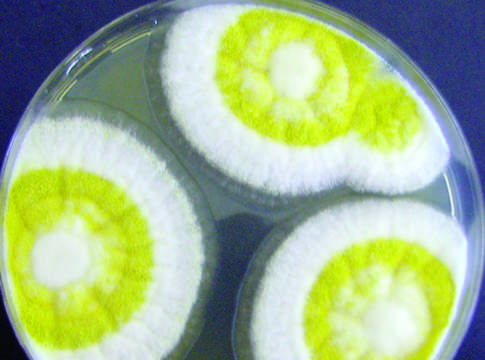
aflatossine

Sandra Osti
Più credito all’innovazione
Banco Popolare punta ai servizi collegati ai bandi Psr in via d’attivazione. Aumentano il peso e l’affidabilità
dei prestiti al comparto primario
L’Europa dei trattori attende ancora la ripresa
Il 2015 si è chiuso con segni negativi in quasi tutti i Paesi dell’Ue. “Brillano” alcuni mercati
mediterranei. In positivo solo Spagna, Francia, Italia e Bulgaria
Emissioni ammoniaca, -14% entro il 2030
In occasione della Fieragricola di Verona ad un convegno sul tema coordinato dal professor Michele Pisante, vicepresidente della Società italiana di agronomia che ha organizzato l’incontro assieme a Edagricole nell’ambito del progetto Nova Agricoltura
Patata, tuberi-seme certificati
A garanzia della purezza varietale, ed esenti da organismi nocivi da quarantena per i quali sono in vigore specifici decreti di lotta obbligatoria
Accordo fra Ministero, Enel e Professionali: energia meno cara
Siglati due accordi a Fieragricola per l’efficienza energetica nella filiera zootecnica
Sostenibilità a tutto campo con l’irrigazione a goccia
Nuovi importanti miglioramenti del materiale impiantistico utilizzato
Mais, in aumento le infestazioni di Sesamia cretica
Cambia il clima e la nottua del mais colonizza la pianura padana
Sostenibilità fitosanitari, alleanza con i contoterzisti
Cai, coordinamento tra Unima e Confai, le associazioni di riferimento delle imprese agromeccaniche, ha fatto il punto sull’applicazione del Pan (piano nazionale per gli usi sostenibili dei prodotti fitosanitari) a Fieragricola di Verona
Riso, 30% del seme non certificato
Delle superfici risicole coltivate e su cui non viene pagata alcuna royalty, unico strumento per sostenere la ricerca, l’innovazione e la competitività del sistema risicolo nazionale
Aflatossine, un nuovo approccio bio
Alla prova una strategia innovativa basata sulla bio-competizione